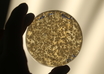

Faster, safer lab score to diagnose heart attacks developed
IANS | Aug 21, 2018
Link discovered between inflammation and depression in type 1 diabetes
ANI | Aug 21, 2018
Antidepressant can delay ageing of brain cells: MIT study
IANS | Aug 21, 2018
Milk at breakfast can help lower glucose levels in diabetics
IANS | Aug 21, 2018
High bad cholesterol ups death risk even for healthy: Study
IANS | Aug 21, 2018
Eating strawberries reduces colonic inflammation, improves gut health in IBD
IANS | Aug 21, 2018
Brain tumours may occur in children with common genetic syndrome
IANS | Aug 20, 2018
Researchers develop new way to grow blood vessels
IANS | Aug 20, 2018
Israeli researchers use soil bacteria to cure fungal infections
IANS | Aug 20, 2018
Autoimmunity can cause COPD: Study
IANS | Aug 18, 2018
Most read this week